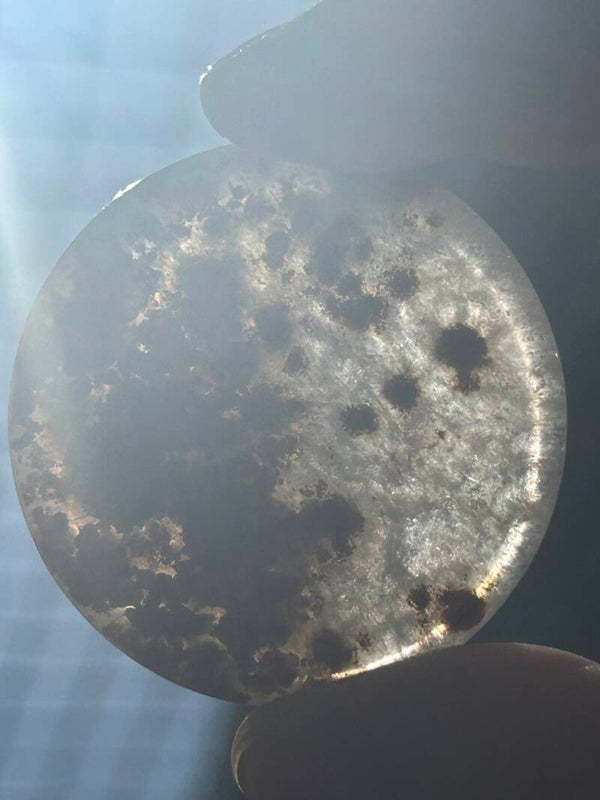

Rode mosagaat in kwarts schijfje
€ 18,00
Een prachtig schijfje van mosagaat
afmeting: 1,7cm
gewicht:29gr
Rode Mosagaat – Groei en Innerlijke Rust
Rode mosagaat combineert de aardende energie van rood met de zachte, helende werking van mosagaat. Bevordert emotionele balans, veerkracht en persoonlijke groei. Wordt vooral gevonden in India en Brazilië.
Rode mosagaat is relatief zeldzamer dan de groene variant, omdat de natuurlijke rode kleur minder vaak voorkomt in combinatie met het kenmerkende mosachtige patroon.